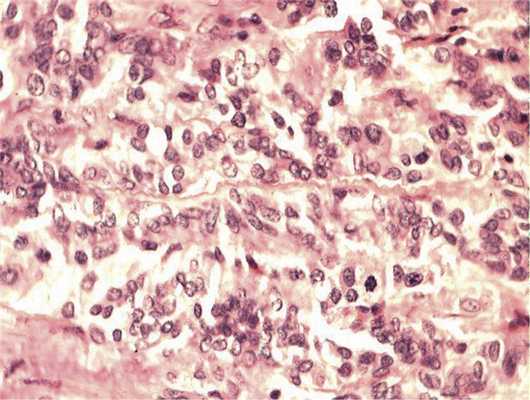

Примеры агрессивной злокачественной медуллоэпителиомы цилиарного тела
Добавил пользователь Владимир З. Обновлено: 01.11.2025
ФГБУН «Институт молекулярной биологии им. В.А. Энгельгардта» Российской академии наук, Москва, Россия;
биологический факультет Московского государственного университета им. М.В. Ломоносова, Москва, Россия
ФГУ Эндокринологический научный центр, Москва
ФГБУ «Национальный медицинский исследовательский центр эндокринологии» Минздрава России, Москва, Россия
ФГБУН «Институт молекулярной биологии им. В.А. Энгельгардта» Российской академии наук, Москва, Россия;
Национальный исследовательский технологический университет «Московский институт стали и сплавов», Москва, Россия
Гистологическая и молекулярно-генетическая характеристика клинически агрессивных вариантов папиллярного рака щитовидной железы
Журнал: Архив патологии. 2019;81(1): 46‑51
Папиллярный рак является наиболее часто диагностируемой формой высокодифференцированного рака щитовидной железы и, как правило, характеризуется благоприятным прогнозом. Однако ряд сравнительно редко встречающихся вариантов данной опухоли, таких как папиллярный рак из высоких клеток, папиллярный рак из столбчатых клеток, диффузно-склерозирующий вариант и недавно описанный рак из клеток типа «сапожных гвоздей», характеризуются менее благоприятным клиническим течением, высокой частотой отдаленного метастазирования и относительно низким уровнем общей и безрецидивной выживаемости. В связи с этим данные варианты важно распознавать на этапе первичного морфологического исследования. В настоящем обзоре литературы рассмотрены морфологические, клинические и молекулярно-генетические особенности вышеперечисленных прогностически неблагоприятных вариантов папиллярного рака щитовидной железы.
Папиллярный рак щитовидной железы (ПРЩЖ) — наиболее часто диагностируемая злокачественная опухоль. Она составляет около 60—90% всех злокачественных новообразований из фолликулярного эпителия [1]. После недавнего введения диагностической категории «неинвазивная фолликулярная опухоль щитовидной железы с ядрами папиллярного типа» (NIFTP — non-invasive follicular thyroid neoplasm with papillary-like nuclear feature) данная оценка будет, по-видимому, несколько скорректирована. Несмотря на высокие показатели общей и безрецидивной выживаемости пациентов с ПРЩЖ, они могут существенно варьировать в зависимости от конкретного гистологического варианта. Данный обзор литературы посвящен особенностям гистологической картины и молекулярной генетики прогностически неблагоприятных вариантов ПРЩЖ, а именно ПРЩЖ из высоких клеток, ПРЩЖ из столбчатых клеток, ПРЩЖ из клеток типа «сапожных гвоздей» (hobnail variant), а также диффузно-склерозирующего варианта ПРЩЖ.
Гистологическая характеристика клинически агрессивных вариантов ПРЩЖ
ПРЩЖ из высоких клеток (tall cell variant)
ПРЩЖ из высоких клеток диагностируют в 3—19% случаев ПРЩЖ [2]. Клетки этого гистологического варианта демонстрируют обильную эозинофильную цитоплазму и четкие очертания, а их длина в 2—3 раза превышает ширину (cм. рисунок, а). Для ПРЩЖ из высоких клеток характерна особенно яркая выраженность типичных ядерных изменений, таких как борозды и псевдовключения; иногда наличие множественных включений в одном ядре создает так называемую картину «мыльных пузырей» (см. рисунок,
ПРЩЖ из высоких клеток встречается у женщин чаще, чем у мужчин, однако соотношение женщин к мужчинам несколько ниже, чем в случае классического ПРЩЖ (2,9 против 4,1 соответственно [4]). Средний возраст пациентов с ПРЩЖ из высоких клеток несколько больше, чем таковых с классическим ПРЩЖ (50,1 против 45,7). В работе Х. Wang и соавт. [4] проведен анализ исследований, посвященных клиническим особенностям ПРЩЖ из высоких клеток, и показано, что средние показатели частот мультифокального поражения, экстратиреоидного распространения, поражения регионарных лимфатических узлов и наличия отдаленных метастазов составляли 45,7, 63,9, 59,3 и 8,6% для ПРЩЖ из высоких клеток и 32,7, 33,5, 33,7 и 3,0% для классического ПРЩЖ соответственно. По данным R. Ghossein и V. Livolsi [5], ПРЩЖ из высоких клеток имеет менее благоприятный прогноз, чем классический ПРЩЖ, вне зависимости от наличия экстратиреоидного распространения. Следует особо отметить, что этот вариант ПРЩЖ составляет значительную часть (до 20%) опухолей щитовидной железы, резистентных к радиойодтерапии [5]. В таблице

Основные патоморфологические и молекулярно-генетические характеристики вариантов ПРЩЖ с агрессивным течением приведены основные клинико-патологические характеристики ПРЩЖ из высоких, столбчатых и клеток типа «сапожных гвоздей», а также диффузно-склерозирующего варианта на основании данных литературы.
Поскольку фокальный компонент из высоких клеток встречается чаще, чем одноименный вариант, одним из острых вопросов является процент высоких клеток, при достижении которого опухоль следует относить к гистологическому варианту ПРЩЖ из высоких клеток. Разными авторами было предложено, что для выделения варианта ПРЩЖ из высоких клеток в отдельный вариант папиллярного рака высококлеточный компонент должен составлять от 10 до 75% опухоли. Согласно классификации ВОЗ 2017 г. [1], данное пороговое значение составляет 30%; эту же цифру приводят и W. Hawk и J. Hazard [6], впервые описавшие данный гистологический вариант в 1976 г.
Пороговое значение в 30% обосновано в исследовании I. Ganly и соавт. [7], в котором 453 пациента были разделены на три группы по степени выраженности высококлеточного компонента (менее 30, 30—49, 50% опухоли и более). Показано, что оптимальным является порог в 30%, поскольку группы пациентов, у которых процент высоких клеток в опухолях составлял 30—49 и 50 и более, не различались по показателям 10-летней болезньспецифической выживаемости и 10-летней выживаемости без возникновения отдаленных метастазов. Кроме того, в опухолях 4 из 6 пациентов из группы с более 30% высоких клеток, умерших от рецидива заболевания, отмечали гистологические признаки снижения дифференцировки вплоть до анапластической трансформации.
В 2015 г. S. Dettmer и соавт. [8] провели сравнительный анализ значимости порогов в 10 и 50% высоких клеток. Результаты исследования 125 случаев ПРЩЖ продемонстрировали, что порог в 10% высоких клеток лучше подходит для выделения наиболее агрессивных опухолей, нежели 50%, поскольку позволяет более строго выделять пациентов с метастатическими поражениями регионарных лимфатических узлов и имеющих более низкую общую выживаемость.
Важность порога в 10% высоких клеток отмечается также в исследовании W. Oh и соавт. [9], которое продемонстрировало, что опухоли, в которых процент высоких клеток составляет 10—30, более агрессивны, чем карциномы с классическим (обычным) типом ПРЩЖ. В этой работе проведено сравнение пациентов с высококлеточным вариантом ПРЩЖ (процент высоких клеток более 30) и пациентов с классическим вариантом ПРЩЖ, содержащим фокальный высококлеточный компонент (10—30%). Исследователям не удалось показать статистически значимые различия между этими группами по (p) T-стадии, наличию экстратиреоидного распространения, отдаленных метастазов и метастазов в дренирующих лимфатических узлах, а также проценту BRAF V600E-позитивных опухолей. Группы классического ПРЩЖ с высококлеточным компонентом (10—30%) и без него существенно различались по этим параметрам между собой.
Таким образом, диагностические критерии выделения варианта ПРЩЖ из высоких клеток по-прежнему остаются предметом обсуждения и, возможно, будут пересмотрены. Большинство авторов сходятся во мнении, что вне зависимости от итогового диагноза (ПРЩЖ из высоких клеток или классический ПРЩЖ) оценка процента фокального высококлеточного компонента опухоли является крайне желательной.
ПРЩЖ из столбчатых клеток
Подобно варианту ПРЩЖ из высоких клеток, цитологической особенностью ПРЩЖ из столбчатых клеток является удлиненная форма клеток, однако эозинофилия цитоплазмы для них нехарактерна. В опухолях данного варианта обычно встречаются крупные суб- и супрануклеарные вакуоли, которые придают гистологическое сходство с эндометриоидной аденокарциномой или аденокарциномой кишечника [1]. Кроме того, столбчатые клетки формируют псевдостратификацию эпителия. Следует особо отметить, что ядра опухолевых клеток не демонстрируют характерные для ПРЩЖ изменения (наличие борозд и псевдовключений). Кроме того, в классификации ВОЗ не приведены данные относительно процента столбчатых клеток, при достижении которого опухоль следует относить к отдельному гистологическому варианту. Типичная гистологическая картина данного варианта приведена на рисунке, в. Опухоли столбчатой цитоморфологии часто экспрессируют транскрипционный фактор CDX2, один из важных регуляторов развития кишечника на ранних стадиях эмбрионального формирования, что отчасти может объяснить столь необычную морфологию клеток этого варианта ПРЩЖ [10—12].
ПРЩЖ из столбчатых клеток встречается чаще у пациентов старшего возраста (средний возраст составляет 53 года, согласно исследованию M. Enriques и соавт. [10], гендерное распределение требует дополнительного исследования, поскольку данные о нем противоречивы (в упомянутой работе соотношение было 10:1, тогда как в работе J.H. Chen и соавт. [13] — 4:5. В исследование J.H. Chen и соавт. [13] включены 9 пациентов, у 5 из которых наблюдалось агрессивное течение заболевания (экстратиреоидное распространение, ларинготрахеальная инвазия, наличие отдаленных метастазов). Спустя 17—45 мес после постановки диагноза 3 из 5 пациентов умерли от опухолевой прогрессии.
ПРЩЖ из клеток типа «сапожных гвоздей» (hobnail variant)
ПРЩЖ из клеток типа «сапожных гвоздей» выделен в отдельный вариант ПРЩЖ сравнительно недавно и встречается в 1—2% [14]. Его чаще диагностируют у людей старшего возраста (средний возраст 54,1 года), соотношение женщин и мужчин ниже, чем у классического ПРЩЖ (3,0 против 4,1) [15]. ПРЩЖ из клеток типа «сапожных гвоздей» обычно представлен папиллярными и микропапиллярными структурами, выстланными клетками с объемной эозинофильной цитоплазмой и ярко выраженным апикальным смещением ядер. В таких клетках отсутствуют межклеточные контакты, располагаются они на поверхности папиллярных структур, подобно «шляпке на ножке» (см. рисунок, г). Согласно текущей классификации ВОЗ, в отдельный вариант ПРЩЖ из клеток типа «сапожных гвоздей» выделяют опухоли, содержащие более 30% клеток соответствующей цитоморфологии [1]. Для ПРЩЖ из клеток типа «сапожных гвоздей» характерны некрозы, большое количество митозов (включая атипичные формы), инвазия за пределы щитовидной железы и в кровеносные сосуды. Из 12 пациентов с этим вариантом ПРЩЖ, обследованных в работе С. Lubitz и соавт. [15], у 7 (58,3%) наблюдалось экстратиреоидное распространение опухоли, а у 9 (75%) — метастатическое поражение шейных лимфатических узлов жировой клетчатки центральной зоны. Кроме того, у 2 пациентов наблюдались небольшие очаги с гистологией недифференцированного (анапластический) рака щитовидной железы.
Сосуществование различных цитоморфологических компонентов ПРЩЖ в пределах одного опухолевого очага
В нескольких работах показано, что участки с цитоморфологическими особенностями вышеописанных агрессивных вариантов ПРЩЖ могут сосуществовать в одном и том же опухолевом очаге (см. рисунок, г и д). Так, в работе С. Lubitz и соавт. [15], посвященной анализу случаев ПРЩЖ из клеток по типу «сапожных гвоздей», из 10 охарактеризованных случаев в 4 (40%) наблюдались очаги из высоких клеток, занимавшие от 20 до 50% опухоли. В работе L. Teng и соавт. [14], описывающей 18 случаев ПРЩЖ из клеток типа «сапожных гвоздей», фокальные компоненты из высоких и/или столбчатых клеток присутствовали в 5 (28%) случаях. В 3 из них столбчатоклеточный компонент занимал 20—30% опухоли, а в оставшихся 2 случаях 10% площади занимал высококлеточный, а 10 и 40% — столбчатоклеточный компонент. Во всех случаях компонент из клеток типа «сапожных гвоздей» наблюдался на более 30% площади опухоли.
Диффузно-склерозирующий вариант ПРЩЖ (diffuse sclerosing variant)
Несколько особняком стоит диффузно-склерозирующий вариант ПРЩЖ, встречающийся в 0,7—6,6%. Данный вариант традиционно считается болезнью молодых (20—30 лет) женщин, в то же время недавно опубликованный метаанализ приводит несколько более высокий показатель среднего возраста, составляющий 41,7 года [16]. В отличие от вышеописанных вариантов ПРЩЖ, выделяемых цитоморфологически, диффузно-склерозирующий вариант определяется в значительной степени гистоморфологически по диффузному вовлечению в опухолевый процесс одной или обеих долей щитовидной железы и отсутствию доминантного опухолевого очага. Такие опухоли демонстрируют обильный фиброз/склероз, выраженную плоскоклеточную метаплазию, множественные псаммомные тельца и обильную лимфоидную инфильтрацию (см. рисунок, е). Для диффузно-склерозирующего варианта ПРЩЖ характерны выраженная лимфоваскулярная инвазия, метастазирование в шейные лимфатические узлы и частое отдаленное метастазирование (преимущественно в легкие). Так, из 35 пациентов с диффузно-склерозирующим вариантом ПРЩЖ, обследовавшихся в работе М. Fukushima и соавт. [17], на момент первичного хирургического лечения у 30 (86%) наблюдались метастазы в регионарных лимфатических узлах, а у 4 (11%) — отдаленные метастазы. На протяжении наблюдения, составляющего 69,5±41,5 мес, у 9 (30%) из 30 пациентов наблюдали рецидив (у 8 из 9 в регионарных лимфатических узлах, у 3 из 9 в легких). Пяти- и 10-летний уровень безрецидивной выживаемости у пациентов с диффузно-склерозирующим вариантом ПРЩЖ значительно ниже такового у пациентов с классическим ПРЩЖ (73,8 и 60,9% против 91,9 и 79,4% соответственно).
Генетические особенности ПРЩЖ с агрессивным течением
По степени дифференцировки рак щитовидной железы принято разделять на высоко-, низко- и недифференцированный. К первому относятся фолликулярный и папиллярный рак. Тем не менее внутри ПРЩЖ различные гистологические варианты также могут быть ранжированы по степени дифференцировки (злокачественности, Grade), исходя из уровня экспрессии тиреоспецифичных генов, что и было сделано N. Agrawal и соавт. [18]. В этом исследовании проведен полногеномный анализ 496 случаев ПРЩЖ, включая 324 (69,4%) случая классического варианта и 35 (7,5%) высококлеточного варианта ПРЩЖ.
Согласно данным N. Agrawal и соавт. [18], степень дифференцировки уменьшается в ряду фолликулярный вариант — классический вариант — высококлеточный вариант ПРЩЖ. В этом же ряду увеличиваются процент опухолей с мутациями BRAF V600E и промотора гена TERT, а также клиническая агрессивность опухолей.
Интересно, что в отличие от других подтипов ПРЩЖ вне зависимости от клинической агрессивности относимых к высокодифференцированному раку ПРЩЖ из клеток типа «сапожных гвоздей» описавшие его авторы относят к умеренно-дифференцированному раку, занимающему промежуточное положение между высоко- и низкодифференцированным раком [19].
Наибольшую частоту мутации BRAF V600E среди ПРЩЖ демонстрирует высококлеточный вариант ПРЩЖ (60—95%). Частота мутации BRAF V600E в ПРЩЖ с клетками типа «сапожных гвоздей» также значительно выше, чем у классического ПРЩЖ, и варьируется от 40 до 90%, по данным разных исследований (L.Teng и соавт. — 94% [14]). В ПРЩЖ из столбчатых клеток мутации в гене BRAF встречаются значительно реже по сравнению с классическим ПРЩЖ (30—35% [11, 13].
Для диффузно-склерозирующего варианта ПРЩЖ характерно наличие транслокаций RET/PTC, процент мутаций BRAF меньше такового при классическом ПРЩЖ и составляет 0—60 в различных исследованиях [16, 20].
Мутации в промоторе гена TERT встречаются в ПРЩЖ достаточно редко. Тем не менее в ПРЩЖ из высоких клеток их процент достаточно велик (около 5—30) [8, 21]. Единственный случай ПРЩЖ из столбчатых клеток, приведенный в работе X. Liu и соавт. [21], был также позитивен по TERT C228T. В исследовании L. Teng и соавт. [14] проведен анализ мутаций в промоторе TERT при ПРЩЖ с клетками по типу «сапожных гвоздей» и обнаружен 1 из 17 случаев, позитивный по мутации TERT C228T. Еще в одном исследовании мутаций в промоторе гена TERT не обнаружено, возможно, это связано с малым размером анализируемой выборки [22]. Анализ мутаций в промоторе TERT при диффузно-склерозирующем варианте ПРЩЖ не проведен.
Таким образом, наличие мутаций в промоторе TERT коррелирует с агрессивным поведением опухоли. Интересно, что пациент с ПРЩЖ из клеток типа «сапожных гвоздей», опухоль у которого была положительна одновременно по мутациям BRAF V600E и TERT C228T, единственный из когорты, умерший от болезни спустя 17 мес после операции [14].
Заключение
В представленной работе рассмотрены морфологические и клинические особенности пациентов с прогностически неблагоприятными вариантами ПРЩЖ. Корректное распознавание данных вариантов является важной составляющей в морфологической диагностике опухолевой патологии щитовидной железы, поскольку выявление любого из них ставит вопрос о необходимости более радикальной лечебной тактики, за исключением случайно выявленных микрокарцином без признаков инвазии в ткани и капсулу щетовидной железы, а также лимфатические и кровеносные сосуды. Открытыми остаются вопросы о клинической и биологической значимости фокальных (менее 30%) компонентов из высоких, столбчатых клеток или клеток типа «сапожных гвоздей». В связи с этим при выявлении соответствующих цитоморфологических изменений их целесообразно отражать в гистологическом заключении с приблизительной оценкой процентного отношения выявленного компонента к общей площади исследованных срезов. К настоящему моменту не выявлено специфических иммуногистохимических или генетических маркеров, позволяющих достоверно отнести опухоль к одному из вышеописанных подтипов, за исключением транскрипционного фактора CDX2, экспрессирующегося практически исключительно в ПРЩЖ из столбчатых клеток. Мутация BRAFV600E встречается с высокой частотой во всех вариантах ПРЩЖ и не может использоваться для дифференциальной диагностики различных вариантов, за исключением фолликулярного, по причине низкой частоты встречаемости мутаций данного онкогена (в большинстве случаев представленных редкими мутациями, отличными от V600E) в этом варианте ПРЩЖ. В то же время частота этой мутации в ПРЩЖ из высоких клеток близка к 100%, что позволяет рассматривать ингибиторы BRAF (вемурафениб, дабрафениб) как весьма перспективные агенты для второй линии терапии радиойодрезистентных случаев данного агрессивного варианта ПРЩЖ.
Обзор литературы подготовлен в рамках реализации научной программы, поддержанной грантом Российского научного фонда № 16−15−10423 (Генетические особенности ПРЩЖ с агрессивным течением) и грантом Российского фонда фундаментальных исследований № 18−315−00168 (Гистологическая характеристика клинически агрессивных вариантов ПРЩЖ).
Медуллоэпителиома цилиарного тела: трудности диагностики
Медуллоэпителиома (МЭ) (диктиоцитома, neuroepithelioma ciliary, диктиома) - редкая врожденная ненаследственная эмбриональная опухоль беспигментного эпителия цилиарного тела 6. Данные литературы основываются в основном на отдельных тематических публикациях с малым количеством пациентов [1, 2, 7]. Выявляется чаще всего у детей первого десятилетия жизни, всегда односторонняя [1, 2, 5, 6]. Она классифицируется как доброкачественная, так и как злокачественная опухоль, в зависимости от степени дифференцировки клеток, митотической активности и наличия выхода опухоли за пределы глазного яблока [4, 8].
Изучить на примере клинического случая трудности диагностики медуллоэпителиомы цилиарного тела.
Материал и методы
Под наблюдением находилась пациентка Ж., 6 лет, которая впервые поступила в детское хирургическое отделение ГАУЗ КО «Кемеровская областная клиническая офтальмологическая больница» с жалобами на изменение цвета зрачка левого глаза (OS).
Из анамнеза: изменения заметили случайно. Осмотр офтальмолога в четыре года патологии не выявил. Со слов родителей, около года назад до обращения в стационар было падение с высоты, была осмотрена травматологом. Кроме того, месяц назад до госпитализации сестра ткнула пальцем в OS, лечились самостоятельно.
При первичном поступлении в июле 2015 г. острота зрения OD=1,0; OS=0. Непостоянное отклонение к виску OS до 10 градусов. При осмотре конъюнктива спокойная. Роговица прозрачная. Передняя камера средней глубины, равномерная. Зрачок круглый в центре. Хрусталик прозрачный, подвывих 1 степени (в условиях максимального мидриаза, в нижне-наружном квадранте). Ретрохрусталиковая фиброзная мембрана, имбибированная форменными элементами крови, конгломератами пигмента, содержит единичные новообразованные сосуды. Глазное дно не офтальмоскопируется. При трансиллюминации через фиброзную пленку получено равномерное розовое свечение. При диафаноскопии в нижне-наружном квадранте тень размерами 0,5 см х1,0 см.
По данным ультразвукового исследования OS: выраженный фиброз стекловидного тела с округлыми полостями, зернистым содержимым, субтотальная отслойка сетчатки. ПЗО OD/OS = 22,46/21,42 мм. ВГД OD/ OS=20/23 мм рт. ст. КЧСМ OS «0». Общая и ритмическая ЭРГ слева не регистрировались. Отмечено снижение амплитуды ЗВП OS.
Пациентка была направлена в ФГБУ «Московский НИИ глазных болезней им. Гельмгольца» МЗ РФ, где проводились обследования. Данных за онкопатологию не выявлено. Осенью 2015 г. диагностирована вторичная гипертензия левого глаза - ВГД=31 мм рт. ст., подобрано гипотензивное лечение, достигнута компенсация.
В дальнейшем пациентка наблюдалась в офтальмологических центрах. Состояние фиброза стекловидного тела расценивалось как исход процесса неясного генеза. Аутоиммунных реакций сенсибилизации к антигенам хрусталика и увеаретинальной ткани выявлено не было. Антител к ВПГ 1 и 2 типа, ЦМВ, ВЭБ, токсоплазмозу, токсокарозу, уреаплазме, хламидиям, микоплазме, туберкулезу не обнаружено.
В июне 2016 г. пациентка вновь обратилась на консультацию в клинику, где диагностирована осложненная набухающая катаракта слева. От предложенной энуклеации родители отказались. Проведена факоаспирация осложненной катаракты без имплантации ИОЛ. В ходе операции проведена ревизия УПК, выявлено полное заращение его за счет массивных гониосинехий, которые не удалось разделить. Проведена дополнительно лазерная иридэктомия OS.
Через месяц после хирургического лечения на плановом осмотре объективный статус без отрицательной динамики. На повторном осмотре через 3 месяца выявлено расширение эписклеральных сосудов. Мелкая, неравномерная передняя камера, иридокорнеальный контакт в нижне-наружных отделах. Субатрофия стромы радужки, сглаженность рисунка крипт. ВГД OS - 38 мм рт. ст. Проведена простая энуклеация OS с последующим гистологическим исследованием. На момент проведения энуклеации анамнез заболевания составил 1 год 2 месяца.
Патогистологическое заключение: в области цилиарного тела определялось опухолевидное образование диаметром 1,5 см. Гистологически опухоль представлена доброкачественной МЭ. Отсутствовало экстраокулярное распространение, не выявлено вовлечение в процесс зрительного нерва.
Результаты и обсуждение
В настоящее время, спустя 2,6 года после энуклеации, состояние ребенка удовлетворительное, признаков рецидива опухоли нет. Пациентка продолжает наблюдение у офтальмолога и онколога.
Представленный клинический случай МЭ цилиарного тела встречается крайне редко. Заболевание часто имитирует увеит, осложненную катаракту, вторичную глаукому [1, 2, 4, 10, 11]. Атипичные проявления опухоли, при отсутствии явной «плюс» ткани, являются диагностической проблемой. Тем не менее при первичном обращении пациентки, такие проявления, как подвывих хрусталика, ретролентальная фиброзная пленка с новообразованными сосудами, отсутствие гипотонии при наличии субтотальной отслойки сетчатки являлись признаками внутриглазного новообразования.
Трудности эхографической диагностики были обусловлены особенностями плоскостного роста и структуры ткани опухоли, которая содержала кисты разных размеров.
Рост опухолевой ткани привел к развитию вторичной гипертензии, осложненной катаракты, выраженных изменений рельефа радужки, глубины передний камеры, иридокорнеальному контакту. В большинстве случаев диагноз внутриглазной МЭ устанавливается несвоевременно, часто опухоль, как и в нашем случае, представляет собой патологоанатомическую находку [1, 2].
Диагностика внутриглазной медуллоэпителиомы является трудной задачей. Сочетание таких клинических признаков как плотная ретролентальная мембрана, подвывих хрусталика, вторичная гипертензия позволяют заподозрить внутриглазную опухоль. Выявление при ультразвуковом исследовании гетерогенной ткани, включающей анэхогенные зоны, подтверждает наличие медуллоэпителиомы.
1. Kaliki S., Shields C.L., Eagle R.C. Jr. et al. Ciliary body medulloepithelioma: analysis of 41 cases. Ophthalmology. 2013; 120(12): 2552-2559.
2. Saunders T., Margo C.E. Intraocular medulloepithelioma. Arch. Pathol. Lab. Med. 2012; 136(2): 212-216.
3. Holdt M., Jurklies C., Schueler A. et al. Intraocular Medulloepthelioma - Series of 10 Cases and Review of the Literature. Klin Monbl Augenheilkd. 2009; 226(12): 1017-1022.
4. Внутриглазные опухоли. Атлас и справочник / Шилдс Д.А., Шилдс К.Л.; пер. с англ. под ред. В.Г. Лихванцевой. М., 2018. 608 с.
5. Боброва Н.Ф., Вит В.В. Атлас врожденных и наследственных заболеваний органа зрения. Одесса, 2006. 140 с.
6. Frederick A.J., Fouad R. Z., Thanos P. et al. Neuroblastic and Astrocytic Differentiation Demonstrated Immunohistochemically in a Small Intraocular Medulloepithelioma. Ocular Oncology Pathology. 2018; 4: 176-181
7.Амирян А.Г., Саакян С.В., Цыганков А.Ю. Внутриглазные медуллоэпителиомы у взрослых и у детей: собственный клинический опыт. Российский общенациональный офтальмологический форум. 2012; 2: 437-441.
8. Саакян С.В., Цыганков А.Ю., Иванова О.А. и др. Злокачественная медуллоэпителиома, симулирующая ретинобластому клинико-гистологический анализ случая и опыт получения клеточной культуры. Вестник офтальмологии. 2016;132(6): 64-69.
9. Owen R.I., Tiffin P.A.C., Steel D.H.W. Echographic features of a case of malignant intraocular medulloepithelioma. Br. J. Ophthalmol. 2005; 89:120-125.
10. Chua J. Commentary on the masquerades of a childhood ciliary body medulloepithelioma: a case of chronic uveitis, cataract, and secondary glaucoma. Journal of Clinical & Experimental Ophthalmology.2016; 7: 543.
11. Pushker N., Bajaj M. S., Singh A.K. et al. Intra-ocular medulloepithelioma as a masquerade for PHPV and Panophthalmitis: a Diagnostic Dilemma. Saudi J. Ophthalmology. 2017; 31:109-111.
Примеры агрессивной злокачественной медуллоэпителиомы цилиарного тела
ФГБУ «Московский НИИ глазных болезней им. Гельмгольца» Минздрава России, Москва
ФГБУ "Московский НИИ глазных болезней им. Гельмгольца" Минздрава России
ФГБУ «Российский научный центр рентгенорадиологии» Минздрава России, Москва, Россия
ФГБУ «Московский НИИ глазных болезней им. Гельмгольца» Минздрава России, ул. Садовая-Черногрязская, 14/19, Москва, 105062, Российская Федерация
ФГБУ «Российский онкологический научный центр им. Н.Н. Блохина» РАМН, 115478 Москва, Каширское шоссе, д. 23
ФГБУ «Российский онкологический научный центр им. Н.Н. Блохина» Минздрава России, Каширское ш., 23, Москва, 115478, Российская Федерация
. Злокачественная медуллоэпителиома, симулирующая ретинобластому — клинико-гистологический анализ случая и опыт получения клеточной культуры
Журнал: Вестник офтальмологии. 2016;132(6): 64‑69
В работе представлен клинико-морфологический анализ случая первичной внутриглазной злокачественной медуллоэпителиомы редкой локализации — центрального отдела сетчатки с вовлечением диска зрительного нерва, — симулирующей ретинобластому, у ребенка 2 лет. Подробно приведены гистологические особенности опухоли (трубчатые и сетчатые структуры опухоли, розетки, ленточные образования, клетки с гиперхромными ядрами, клеточный полиморфизм). Описан единственный на сегодняшний день в Российской Федерации опыт создания первичной культуры внутриглазной злокачественной медуллоэпителиомы с последующей оценкой чувствительности (МТТ-тест) к четырем препаратам (оксалиплатин, иринотекан, ифосфамид, аскорбиновая кислота) в различных концентрациях. Из четырех исследованных препаратов IC50 (3,3 мг/мл) получена только для раствора аскорбиновой кислоты. Несмотря на относительную редкость первичной внутриглазной злокачественной медуллоэпителиомы, необходимо проводить дифференциальный диагноз с другими внутриглазными образованиями, прежде всего ретинобластомой. Полученные данные об эффективности раствора аскорбиновой кислоты в отношении клеток внутриглазной злокачественной медуллоэпителиомы могут быть использованы для дополнения существующих химиотерапевтических протоколов в детской нейро- и офтальмоонкологии.
Внутриглазная медуллоэпителиома (диктиома) — редкая врожденная эмбриональная опухоль, растущая из эпителия цилиарного тела, ресничной части сетчатки и зрительного нерва, которая встречается как у взрослых, так и у детей [1, 2]. Опухоль состоит из тубулярных структур, выстланных псевдомногослойным нейроэпителием. Данная опухоль чаще всего выявляется в первой декаде жизни. Диагностика медуллоэпителиомы не всегда очевидна. Эхографическая локализация зачастую затруднена в связи с плоскостным характером роста, что объясняет позднюю (послеоперационную) диагностику [3].
В литературе за последние 30 лет доступны лишь 10 работ, посвященных первичной внутриглазной медуллоэпителиоме диска зрительного нерва (ДЗН) [2, 4, 5]. В работе Pastora-Salvador и соавторов описан случай медуллоэпителиомы зрительного нерва у мальчика 12 лет. Пациенту провели локальную резекцию опухоли, при этом безрецидивный период наблюдения составил 25 лет [5].
Медуллоэпителиомы классифицируются на тератогенные и нетератогенные варианты, подразделяемые в свою очередь на доброкачественные и злокачественные типы. Основной признак нетератогенного типа опухолей — множественность слоев и полос низкодифференцированных нейроэпителиальных клеток, внешне схожих с эмбриональной сетчаткой или цилиарным эпителием [6].
Дифференциальный диагноз следует проводить с ретинобластомой и другими редкими внутриглазными опухолями, включая беспигментную меланому, шванному и аденокарциному ретинального пигментного эпителия, а также неопухолевыми процессами, такими как воспалительная гранулема [7, 8]. Несмотря на то что медуллоэпителиомы могут выглядеть в виде крупных нейробластных псевдорозеток, для них характерны трубчатые конгломераты клеток, а не рост в виде «перчаток» или «рукоятки», что типично для ретинобластом. Дифференциальными признаками могут служить также тесная взаимосвязь с подлежащими тканями и отсутствие псевдофоторецепторов, в отличие от розеток Флекснера—Винтерштайнера [6]. Иммуногистохимические исследования медуллоэпителиом с псевдорозетками Флекснера—Винтерштайнера выявляют положительный результат на нейронспецифичную енолазу и синаптофизин во всех случаях [6].
В некоторых случаях исход заболевания неблагоприятен. Такое развитие новообразования чаще всего связано с распространением за пределы глаза, но также описаны отдаленные метастазы в лимфатические узлы, околоушные железы, легкие и средостение [9]. Медуллобластома как примитивная нейроэктодермальная опухоль центральной нервной системы у детей поражает преимущественно мозжечок и встречается значительно чаще первичной опухоли внутри глаза [10]. На сегодняшний день доступны несколько химиотерапевтических протоколов для лечения данного заболевания [11]. Первичная внутриглазная медуллоэпителиома, несмотря на низкую частоту встречаемости, представляет интерес для офтальмологов в связи со сложностью ее дифференциальной диагностики с другими внутриглазными новообразованиями, а также единичными данными о возможном химиотерапевтическом лечении.
Цель настоящей работы — клинико-гистологический анализ случая злокачественной медуллоэпителиомы у ребенка, а также описание опыта получения клеточной культуры опухоли и проведения МТТ-теста.
Клинические данные. Мальчик в возрасте 2 лет и 3 мес поступил на обследование и лечение в стационар. Из анамнеза известно, что в возрасте 2 лет родители заметили изменение «окраски» зрачка левого глаза на фотографии, а через 2 мес обратились к врачу по месту жительства, диагноз — подозрение на ретинобластому группы D. До появления первых симптомов ребенка осматривали в 1 год и 7 мес, но без мидриаза. При поступлении острота зрения на левом глазу соответствовала правильной проекции света, передний отрезок глаза без изменений. На глазном дне, по данным осмотра на RetCam, — ДЗН и макула не определяются, прикрыты серо-белой опухолевой тканью с неровными границами и бугристой поверхностью (рис. 1). На правом глазу изменений не выявлено.

Рис. 1. Клиническая картина опухоли при осмотре на RetCam.
Согласно данным ультразвукового исследования, у заднего полюса выявлены плюс-ткань гетерогенной эхоструктуры с единичными кальцинатами, размером 6,4×13,3 мм, вторичная отслойка сетчатки (рис. 2). Учитывая локализацию опухоли (солитарный опухолевый узел, полностью перекрывающий ДЗН), отсутствие шансов на зрение, размеры образования и высокий риск экстрабульбарного распространения опухоли, выполнена энуклеация левого глаза с пластикой культи. После получения патогистологического заключения (злокачественная медуллоэпителиома) ребенок направлен на консультацию к детскому онкологу с целью возможного выявления новообразования в головном мозге. По данным магнитно-резонансной томографии, опухолевых очагов в ЦНС не выявлено, однако в связи с прорастанием опухоли за laminacribrosa пациенту назначен курс лучевой и химиотерапии (циклофосфан, вепезид, карбоплатин).

Рис. 2. Результат эхографии левого глаза у ребенка с подозрением на монокулярную форму ретинобластомы.
Патоморфологическое исследование. При морфологическом исследовании кусочка новообразования из боковой колодки выявлена опухоль, состоящая из кубических эпителиальных клеток, которые формировали единичные розетковидные структуры и небольшие участки солидного роста. Поставлен предварительный диагноз — недифференцированная ретинобластома без опухолевых комплексов в дистальном отрезке зрительного нерва. Далее при изучении срезов всего глазного яблока выявлен большой опухолевый узел в центральных отделах глазного дна, тесно связанный со зрительным нервом. Узел состоял преимущественно из трубчатых и сетчатых структур, розеток, ленточных образований, что придавало опухоли местами вид «кружева» (рис. 3).

Рис. 3. Часть узла опухоли снаружи от ДЗН, имеющая вид «кружева». Окраска гематоксилином и эозином. Ув. 100.
Отмечалось наличие ленточных структур из низкодифференцированных эпителиальных клеток (рис. 4). Параллельно встречались участки солидного строения из клеток с гиперхромными ядрами с признаками клеточного и ядерного полиморфизма. В них почти исчезает строма, появляются митозы, встречаются участки дистрофии и некроза (рис. 5). Опухоль врастает в ткань ДЗН с переходом за laminacribrosa, но не достигает линии отсечения (рис. 6). В таком виде опухоль обладает местнодеструирующим характером роста и может давать метастазы, глубоко инфильтрируя прилежащую к ДЗН ткань хориоидеи. Окончательный гистологический диагноз: злокачественная медуллоэпителиома центрального отдела сетчатки с вовлечением ДЗН и инвазией перипапиллярной хориоидеи, с глубоким прорастанием по зрительному нерву, не достигая линии отсечения.

Рис. 4. Формирование полос из низкодифференцированных нейроэпителиальных клеток. Окраска гематоксилином и эозином. Ув. 400.
Рис. 5. Зоны солидного роста опухоли. Клеточный полиморфизм с фигурами митозов. Окраска гематоксилином и эозином. Ув. 400.

Рис. 6. Врастание опухоли в ткань ДЗН с ростом по ходу пучков нервных волокон. Окраска гематоксилином и эозином. Ув. 100.
Получение первичной культуры опухоли. После вскрытия глазного яблока взят образец опухолевой ткани для получения клеточной культуры с последующим исследованием лекарственной устойчивости (МТТ-тест). Опухолевый образец транспортировали в лабораторию генетики опухолевых клеток РОНЦ им. Н.Н. Блохина в течение 2—3 ч в бессывороточной среде RPMI («ПанЭко», Россия) с добавлением 100 мкг/мл гентамицина («Микроген», Россия). Далее полученную ткань обрабатывали механически (измельчали стерильными ножницами) и ферментативно (0,25% трипсин—0,04% ЭДТА; «ПанЭко», Россия) до получения клеточной суспензии, которую переносили в культуральные флаконы («Corning—Costar», США) со средой RPMI c добавлением 10% эмбриональной сыворотки коров («PAALaboratories», Австрия) и гентамицина 50 мкг/мл. Центрифугировали транспортировочную среду, полученный осадок клеток высевали на флаконы, которые помещали в термостат («Memmert», Германия) при температуре 37 °C и содержанием 5% СО2. Далее в течение 1 мес культивировали полученные клетки, по мере необходимости закисленную среду с погибшими клетками заменяли на новую питательную среду, при достижении клетками 60—80% уровня конфлюэнтности производили рассев клеток на новые культуральные флаконы. В течение культивирования клетки прошли 2—4 пассажа.
МТТ-тест. Метод основан на способности митохондриальных дегидрогеназ живых клеток метаболизировать желтый тетразол-реагент МТТ-3-(4,5-диметилтиазол-2)-2,5-дифенилтетразол-бромид в синий формазан. По интенсивности окраски конечного раствора судят о количестве живых клеток в лунке.
Клетки первичной культуры медуллоэпителиомы MB1 рассевали на 96-луночное плато по 1,5∙10 3 клеток в лунку в объеме 90 мкл культуральной среды RPMI. Препараты (иринотекан, ифосфамид, оксалиплатин и аскорбиновую кислоту) в объеме 10 мкл добавляли в различных концентрациях на следующий день. В контрольные лунки добавляли 10 мкл бессывороточной среды. Клетки культивировали в присутствии химиопрепаратов в течение 3 сут. Затем в лунки добавляли реагент МТТ в концентрации 5 мг/мл в объеме 20 мкл на лунку (рис. 7). Через 1,5—2 ч среду с реагентом удаляли и осадок растворяли в 60 мкл ДМСО. Уровень оптической плотности растворов в каждой лунке определяли с помощью спектрофотометра (планшетного ридера) Multiskan FC («ThermoScientific», EС) при длине волны 594 нм.

Рис. 7. 96-луночное плато с клетками первичной культуры злокачественной медуллоэпителиомы и исследуемыми препаратами.
Далее в «Программе для расчета IC50 химиотерапевтических веществ», написанной в лаборатории генетики опухолевых клеток, строили график зависимости уровня оптической плотности (проценты от контроля) от концентрации вещества и рассчитывали искомую концентрацию IC50 (полумаксимальное ингибирование). Использованы следующие химиопрепараты:
а) Иринотекан («Actavis», Исландия) в концентрациях 0,25; 0,5; 1,0 и 2,0 мг/мл;
б) Ифосфамид («Верофарм», Россия) в концентрациях 0,25; 0,5; 1,0 и 5,0 мг/мл;
в) Оксалиплатин («Medac», Германия) в концентрациях 0,1; 0,2; 0,38; 0,75 и 1,5 мг/мл;
г) Аскорбиновая кислота («Alvils», Россия—Китай) в концентрациях 0,6; 1,25; 2,5 и 5 мг/мл.
Результаты МТТ-теста представлены на рис. 8, а—г. Для аскорбиновой кислоты получена IC50 3,3 мг/мл. Результаты данного теста показывают, что с повышением концентрации препарата выживаемость клеток увеличивается.

Рис. 8. IC50 (полумаксимальное ингибирование). а — для аскорбиновой кислоты; б — для оксалиплатина; в — для иринотекана; г — для ифосфамида.
IC50 для оксалиплатина, иринотекана и ифосфамида не получена. Для оксалиплатина при минимальной используемой концентрации 0,1 мг/мл выживаемость клеток составила 36%, для иринотекана при минимальной используемой концентрации 0,25 мг/мл — 29%, а для ифосфамида при максимальной используемой концентрации 5 мг/мл — 64%. Таким образом, из четырех исследованных препаратов IC50 (3,3 мг/мл) получена только для раствора аскорбиновой кислоты.
К настоящему времени патогномоничные симптомы, свидетельствующие о первичной внутриглазной злокачественной медуллоэпителиоме, не описаны, а диагноз ставится на основании патогистологического заключения. Вместе с тем ряд симптомов, включая наличие кальцификатов и нехарактерные рентгенографические признаки, затрудняют дифференциальную диагностику с другими внутриглазными опухолями детского возраста, прежде всего ретинобластомой. К характерным патоморфологическим особенностям ретинобластомы, отличающим ее от медуллоэпителиомы, относят наличие «истинных» розеток, состоящих из цилиндрической формы нейроэпителиальных клеток эмбрионального типа [12]. Для медуллоэпителиомы, напротив, характерно наличие псевдорозеток, располагающихся диффузно или вокруг сосудов [2]. Несмотря на относительную редкость опухоли, необходимо проводить дифференциальный диагноз с другими внутриглазными образованиями, особенно при наличии сопутствующих длительно существующих глазных симптомов. Полученные данные об эффективности раствора аскорбиновой кислоты в отношении клеток внутриглазной злокачественной медуллоэпителиомы могут быть использованы для дополнения существующих химиотерапевтических протоколов в детской нейро- и офтальмоонкологии. Клеточная культура медуллоэпителиомы и возможная животная модель опухоли являются потенциальными объектами для изучения как экспрессии генов, так и специфических мутаций в ткани опухоли, что в свою очередь представляет интерес в перспективе для селективной химиотерапии опухоли и сохранения глаза.
ФГБУ "НИИ нейрохирургии им. акад. Н.Н. Бурденко" РАМН, Москва
ГУ ФНКЦ детской гематологии, онкологии и иммунологии Минздрава РФ им. Д. Рогачева, Москва
ФГБНУ «НИИ нейрохирургии им. акад. Н.Н. Бурденко», Москва, Россия
НИИ нейрохирургии им. акад. Н.Н. Бурденко РАМН, Москва
ФГБУ "НИИ нейрохирургии им. акад. Н.Н. Бурденко" РАМН
Медуллоэпителиома, эпендимобластома и эмбриональная опухоль с истинными розетками - единая нозологическая единица?
Журнал: Журнал «Вопросы нейрохирургии» имени Н.Н. Бурденко. 2013;77(6): 51‑55
Рыжова М.В., Кушель Ю.В., Желудкова О.Г., Шишкина Л.В., Панина Т.Н., Меликян А.Г., Землянский М.Ю., Леменева Н.В. Медуллоэпителиома, эпендимобластома и эмбриональная опухоль с истинными розетками - единая нозологическая единица? Журнал «Вопросы нейрохирургии» имени Н.Н. Бурденко. 2013;77(6):51‑55.
Ryzhova MV, Kushel' IuV, Zheludkova OG, Shishkina LV, Panina TN, Melikian AG, Zemlianskiĭ MIu, Lemeneva NV. Are the medulloepithelioma, ependymoblastoma and embryonal tumor with multilayered rosettes the same entity? Zhurnal Voprosy Neirokhirurgii Imeni N.N. Burdenko. 2013;77(6):51‑55. (In Russ., In Engl.).
Медуллоэпителиома - чрезвычайно редкая злокачественная преимущественно супратенториальная опухоль головного мозга. Гистологически медуллоэпителиома характеризуется эпителиальными структурами, подобными примитивному эпителию развивающегося мозга. Иммуногистохимическое исследование опухоли выявило положительную экспрессию LIN28A, а флуоресцентная гибридизация in situ - амплификацию микро-РНК на локусе 19q13. Имеющиеся в опухолевом геноме аберрации позволяют нам предполагать, что медуллоэпителиома, также как и эпендимобластома и эмбриональная опухоль с обилием нейропиля и истинными розетками, представляют собой единую нозологическую единицу.
Медуллоэпителиома — это редкая высокозлокачественная опухоль, возникающая у детей младшего возраста и поражающая преимущественно большие полушария головного мозга, относящаяся согласно классификации ВОЗ опухолей центральной нервной системы наряду с нейробластомой ЦНС, ганглионейробластомой ЦНС и эпендимобластомой к примитивным нейроэктодермальным опухолям WHO Grade IV [8].
Также медуллоэпителиома может поражать цилиарное тело, сетчатку и зрительный нерв, прогноз у медуллоэпителиомы глаза при энуклеации глазного яблока относительно благоприятный [3, 5, 11, 12].
Гистологически медуллоэпителиома характеризуется эпителиальными структурами (тубулярными, трабекулярными и папиллярными), подобными примитивному эпителию развивающегося мозга. Эпителий ограничен с внутренней стороны люминальной поверхностью, близко к которой обычно располагается большое количество митозов, и наружной лимитирующей мембранной. Медуллоэпителиомы могут демонстрировать различную дифференцировку, в том числе нейрональную и нейробластическую, астроцитарную, олигодендроглиальную, мезенхимальную, описаны медуллоэпителиомы с наличием пигмента меланина, также для этих опухолей характерно появление истинных многорядных розеток, сходных с эпендимобластическими розетками [3, 4, 9, 12].
Согласно текущей классификации опухолей [8] и данным экспертов в области нейропатоморфологии [3, 4, 9, 12], дифференциальный диагноз следует проводить с эпендимобластомой, карциномой сосудистого сплетения, незрелой тератомой и атипической тератоидно/рабдоидной опухолью.
Редкость возникновения медуллоэпителиом делает описание каждого наблюдения особенно важным, тем более, что представленные в мировой литературе данные характеризуют лишь морфологические особенности [2, 13], молекулярно-генетические аберрации медуллоэпителиом остаются не изученными до сих пор.
Мы надеемся, что наше наблюдение будет способствовать пониманию биологических особенностей этого новообразования.
Клинический случай
Мальчик в возрасте 1 года 10 мес поступил во II детское отделение ФГБУ «Научно-исследовательский институт нейрохирургии им. акад. Н.Н. Бурденко» с гигантской опухолью левого полушария головного мозга. Ребенок от первой беременности, протекавшей без патологии, первых самостоятельных родов на 37-й неделе. Масса тела при рождении 2750 г, рост 49 см. Мальчик развивался с отставанием в моторном развитии: начал переворачиваться в 6 мес, ползать и сидеть в 7 мес, ходить в 1 год 1 мес. Заболел в возрасте 1 года 7 мес, когда на фоне подъема температуры до 38 °С стал прихрамывать на правую ногу. Проведенная компьютерная томография (рис. 1)

Рисунок 1. Компьютерная томография гигантской опухоли левого полушария головного мозга. выявила гигантскую опухоль левого полушария головного мозга. Также за прошедшие 3 мес отмечен активный прирост окружности головы. В клинической картине заболевания доминировали симптомы внутричерепной гипертензии в виде прогрессирующей макрокрании (окружность головы 60 см), на глазном дне были выявлены признаки внутричерепной гипертензии с развитием атрофии зрительных нервов и слепоты. Также обращала на себя внимание очаговая симптоматика преимущественного поражения левого полушария: ограничение взора влево, центральный парез VII нерва справа, тетрапарез до 4 баллов слева и до 3 баллов справа, рефлексы D>S, диссоциация по оси тела и координаторные расстройства с развитием выраженной атаксии, при этом движения в конечностях были сохранены в полном объеме. Мальчику было проведено тотальное удаление гигантской опухоли, имеющей достаточно хорошую псевдограницу с веществом мозга. После гистологической верификации опухоли ребенок и его родители были консультированы онкологом: было рекомендовано проведение высокодозной химиотерапии. Через 3 мес после постановки диагноза ребенок умер от прогрессии заболевания.
Материал и методы
Флуоресцентная гибридизация in situ (Fluorescence in situ hybridization, FISH) была проведена с коммерческой пробой Vysis Abbott Molecular Vysis LSI N-MYC (2p24) Spectrum Green/CEP 2 Spectrum Orange Probe и некоммерческой двухцветной пробой: FITC-меченной пробой 634C1 к локусу 19q13.42 и контрольной дигоксигенинмеченной пробой 2659N к локусу 19р13.
Патоморфологическое и молекулярно-генетическое исследования
За исключением небольших замороженных во время операции фрагментов опухоли был исследован весь присланный материал, составивший 12 парафиновых блоков. Гистологическое исследование показало достаточно однородную по морфологической картине злокачественную опухоль с обширными полями некрозов. Клетки опухоли формировали нейроэпителиальные структуры: каналы, полости и трабекулы, подобные нервной трубке эмбриона. Также в опухоли встречалось большое количество истинных многорядных розеток с фигурами митозов
Рисунок 2. Медуллоэпителиома. Гистологические препараты. а — общий вид опухоли, формирующей эпителиальные структуры (голубые стрелки) и истинные розетки (желтая стрелка). × 10; б — структуры, подобные нервной трубке (красные стрелки), и истинные розетки (голубая стрелка). × 30. Окраска гематоксилином и эозином. Участки нейропиля в опухоли отсутствовали. Иммуногистохимическое исследование выявило положительную экспрессию LIN28А (рис. 3), Рисунок 3. Медуллоэпителиома. Иммуногистохимическое исследование с антителом LIN28A. Тотальная положительная экспрессия в клетках опухоли. виментина, очаговую положительную экспрессию цитокератинов АЕ1/3 и СК18 (рис. 4); Рисунок 4. Медуллоэпителиома. Иммуногистохимическое исследование с эпителиальным маркером цитокератином СК18. Фокальная положительная экспрессия в клетках опухоли. тотальную ядерную экспрессию INI1, что свидетельствовало об отсутствии делеции гена INI1 и исключило атипическую тератоидно-рабдоидную опухоль. Экспрессии глиофибриллярного кислого белка GFAP, S-100, синаптофизина, нейронспецифической енолазы NSE, эпителиального мембранного антигена EMA и альфа-фетопротеина выявлено не было. Флуоресцентная гибридизация in situ демонстрировала кластерную амплификацию микро-РНК локуса 19q13 (рис. 5), Рисунок 5. Флуоресцентная гибридизация in situ с некоммерческой двухцветной пробой. FITC-меченной пробой 634C1 к локусу 19q13.42 и контрольной дигоксигенинмеченной пробой 2659N к локусу 19р13 выявлена кластерная амплификация микро-РНК локуса 19q13.42 (множественные сливные зеленые сигналы). Вверху в центре имеется канал (зеленые стрелки) структура, подобная примитивному эпителию развивающегося мозга; внизу слева (красная стрелка) — истинная многорядная розетка. количественных изменений на хромосоме 2 не наблюдалось (сбалансированный профиль хромосомы 2) (рис. 6). Рисунок 6. Флуоресцентная гибридизация in situ с пробой Vysis к онкогену N-MYC (локус 2p24)/центромера 2 не выявила добавки хромосомы 2. В центре — истинная многорядная розетка (показано стрелкой).
Медуллоэпителиома — чрезвычайно редкая злокачественная преимущественно супратенториальная опухоль головного мозга. За период с 2000 по 2013 г. в отделении патологической анатомии ФГБУ «Научно-исследовательский институт нейрохирургии им. акад. Н.Н. Бурденко» РАМН было диагностировано только 2 случая медуллоэпителиомы: текущий случай, а также клиническое наблюдение за 2006 г. В то же время диагноз примитивной нейроэктодермальной опухоли ЦНС за прошедшие почти 13 лет был поставлен в 100 случаях, среди которых было 19 первично диагностированных эмбриональных опухолей с обилием нейропиля и многорядными розетками ETMR (одна из самых больших серий в мире, собранных в одном лечебном учреждении).
По мнению некоторых авторов [2], в случае рецидива ETMR опухоль приобретает строение более сходное с медуллоэпителиомой. Нами [1] также описано подобное явление. Но в данном случае речь идет о первичной медуллоэпителиоме, демонстрирующей биологические особенности, идентичные выявляемым в ETMR: амплификацию микро-РНК на локусе 19q13 [6] и тотальную экспрессию опухолевыми клетками LIN28A [7]. Имеющиеся в опухолевом геноме аберрации позволяют нам вслед за S. Nobusawa и соавт. [10] предполагать, что медуллоэпителиома, как и эпендимобластома и эмбриональная опухоль с обилием нейропиля и истинными розетками, представляет собой единую нозологическую единицу.
Благодарности
Авторы сердечно благодарят проф. А.Г. Коршунова (Clinical Cooperation Unit Neuropathology, German Cancer Research Center (DKFZ), Heidelberg, Германия) за оказанную поддержку и добрые советы и Prof. Dr. S. Pfister (Division of Pediatric Neurooncology, German Cancer Research Center (DKFZ), Heidelberg, Германия) за любезно предоставленную пробу для FISH-исследования микро-РНК локуса 19q13.42/19р13 и поликлональное антитело LIN28A. Также мы благодарим И.В. Зубову и Т.М. Коршунову за высокопрофессиональное техническое исполнение иммуногистохимического исследования и флуоресцентной гибридизации in situ.
Читайте также:
